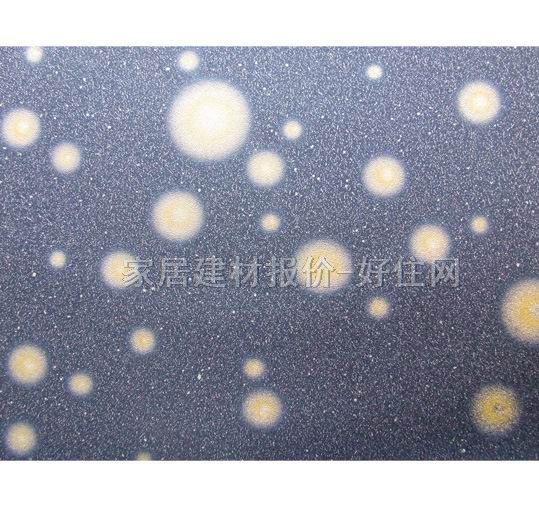
���� UB05181 0.53��10M �AȦ �{ɫ

|
|
|||||||||||||||||||||||||||||||||||||||||||||

選購墻紙重要指南:
選購墻紙重要指南:
1、即看花色更要關心材質
市場上壁紙花色繁多,但材質也很多,其中紙基PVC壁紙占一大半,原材料成本相對比較低,一些進口PVC壁紙標價很高,所以侃價時不要太客氣,這類壁紙可以通過撕(有明顯的兩層結構,表層有彈性)、燒(有黑色濃煙和刺鼻的味道)等方法簡單鑒別出來。
2、既看品牌也看價格
現在大家看到的壁紙店基本是店名(部分是以店內銷售的其中一個壁紙品牌來命名),真正的單一壁紙品牌專賣店是極少的,要問清他們每個店一手代理的品牌或主打什么品牌,這樣得到的價格才可能最真實最靠譜,當今許多樣本在各店重復銷售重復加價的現象非常常見。買裝修材料一定要了解它的品牌和歷史,他們提供的產品和售后服務基本可以放心,壁紙行業真正稱得上是品牌的并不多,單一品牌最起碼要有產品介紹冊,樣本上要有統一的LOGO標識(原廠印刷而非后貼上去的),最好要有相關品牌的網站(國際品牌有中文和國外的網址)。
3、重視墻紙的環保性能
壁紙的環保高低取決于材質和用料檔次、印刷工藝等方面,有條件現場可通過燃燒小樣(環保等級高的壁紙沒有燃燒異味沒有濃煙,灰燼是灰色粉末裝)和聞(PVC壁紙有明顯的塑膠味、檔次低的壁紙有很濃的印刷油墨味)來鑒別,檢測報告存有水分,并不能說明問題,新開卷且沒有異味的紙漿壁紙環保等級是最高的,我們建議您兒童房不要用PVC壁紙。
4、注重圖案的色牢度
色彩艷麗顏色鮮艷的壁紙固然漂亮,但千萬別忘了現場用濕布擦拭一下,看看是否脫色,尤其是一些有凹凸紋理的壁紙,日后少不了經常清潔打理。
5、買壁紙特別要關注配套輔料
挑選壁紙的同時,也要了解一下基膜(墻體封底用)、膠粉、膠漿的使用功能,它們會直接影響壁紙的施工質量和后期效果,如果您不想再為售后傷腦經,那么我們建議您一定不要選擇不知名的輔料,還要小心一些商家在輔料上宰你一刀(壁紙往往很便宜)。
6、注重壁紙的長久視覺效果
一定要想到壁紙是每天要面對的,有些壁紙小幅好看,但上墻后效果差(反之亦然);有些壁紙單幅漂亮但需要搭邊貼(現場要了解清楚),影響實際整體視覺感;有些壁紙開始看漂亮(尤其是圖案艷麗的壁紙),經常看會很快視覺疲勞會膩眼(反之亦然),所謂好看不一定耐看,耐看不一定開始好看,就是這個道理。所以我們不建議您選擇表面發亮的壁紙。
7、抓住最后一道施工和售后服務環節
因材質不同,壁紙施工手法(如一些壁紙要搭邊)和難易程度也不同,現在的壁紙商家和壁紙施工基本上都是松散的合作關系,施工質量真正出了問題就會推諉、扯皮,所以要了解您接觸的壁紙商家有沒有屬于自己專業的施工隊伍。
墻紙的損耗和壽命
小卷壁紙一般是0.53米寬,10米長一卷,整卷出售不裁零。在實際粘貼中,壁紙存在10%-20%的合理損耗,大花壁紙的損耗更大,因此在采購時應留出消耗量。同時壁紙的施工技術比較復雜,一定要找專業的工人來鋪裝。再有貼壁紙的墻面一定不能刷防水乳膠漆。據有關專家介紹,現代工藝生產的壁紙在正常條件下可,使用壽命為8-10年。作為一種裝飾性材料,壁紙本身具有很強的時代感。據調查,在國外,壁紙的更新速度相當的快,使用1-2年,壁紙就可能會被更換。換款壁紙,就在換個心情。
墻紙的施工要點:
想將壁紙貼得好,還要掌握兩個要素:一是要選擇優質的墻紙和墻紙粉,墻紙粉也是如此,應選擇一些具有防霉、耐久性能的產品,如果廠家取得ISO9002質量認證,就更加有保證。
其次就是施工時要注意墻面的處理。施工前要確保墻面光滑、平整及干燥,最好先涂上一層光油。新建的樓房由于墻壁濕氣重,更應注意墻面的防潮。近年來,國內一些有實力的生產廠家不斷改良工藝,提高產品質量,甚至采用加厚的原紙,使墻紙的施工性能大大提高,對墻面的要求也相對降低了
1.先將墻面找平,打膩子,膩子干后將墻面用砂紙磨平,底層涂上膠水,起防潮、致密墻面的作用。
2.然后把裁好的墻紙放在水中浸泡5分鐘左右取出,刷上專用墻紙膠,用刮刀將墻紙緊貼在墻上,用抹布抹平排除氣泡
3.再將下一張墻紙重疊2厘米貼上,在重疊部分用紙刀從上而下裁斷,撕去余紙,使拼接處無縫,最后用濕毛巾將拼縫處的多余膠水擦凈。裱糊完工后的墻紙對花嚴密,平整美觀,人站在離墻約1.5米以外目測,應看不出接縫,無氣泡褶皺。
貼墻紙的工具、材料:
4"大油掃 墻紙 墻紙刮糊粉(墻紙專用) 1"鋁壓尺化白水 小介刀光油 濕白色毛巾天拿水
貼墻紙的具體做法:
首先用化白水按1:10比例加水,涂上墻,盡快於未乾前鏟除舊油漆批蕩,重新批蕩。在己批蕩好的墻上,涂上一層光油,可防潮。記住光油要加入1:1比例的天拿水稀釋;記住待乾透后才可貼紙。量度墻紙的尺寸,預留至少4厘米;用油掃將漿糊均勻涂掃在墻紙背面,約5分鐘后貼上,先從墻紙中間開始,頂端要預留2厘米; 用墻紙刮由內向外輕掃,務求消除氣泡和皺紋。用濕毛巾將墻紙邊緣或墻紙之間的漿糊抹清;用刀小心切除多出來的紙邊。
貼壁紙前的準備工作
1、貼壁紙之前,補好墻上的裂縫和凹坑,尤其是有壁燈處更要補好,因為在壁燈照耀下,壁紙下的瑕疵會很明顯。盡量先把房間打掃干凈,如有可能,卸下擱板,拆下燈具。在地板上鋪上防塵布,不要鋪聚乙烯布,因為一沾水會變得很滑
2、在墻面上膠漿。在墻面先上一層膠漿,可防止墻面吸收粘合劑而使墻紙粘不牢,也可使墻面變得滑溜,便于把墻紙滑到正確的位置。上什么漿料可查閱墻紙上的說明。
3、用涂粘合劑的刷子,把漿料均勻地涂在整個墻面上。若漿料沾到上過漆的木構件上,要馬上用濕布或海綿擦掉,否則一凝固就很難除掉了。
調制粘合劑
根據墻紙種類選擇合適的粘合劑,照說明書調制。
1.先在桶中倒入規定數量的冷水,然后慢慢加入所需數量的粘合劑粉充分攪勻,不要結塊。
2.一般調好后須過15分鐘才可使用,但有的立即可用。
裁剪壁紙
1.取一卷墻紙,看清花紋的方向,決定哪一方向朝上。
2.以踢腳板的頂端為起點,用鋼卷尺量出墻壁的高度。同一房間中不同地方量得的高度可能不同,因此須量幾個地方,取最大值,再加上4寸作為兩頭修裁之用。
3.把墻紙在涂粘合劑的桌子上展開,正面朝下,量好長度,用鉛筆在背面畫一條線。
4.用剪刀沿線將墻紙剪開。
5.把剪好的墻紙翻個面,把余下的墻紙再展開一段,與反面的墻紙邊角對齊,圖案對齊。以第一張墻紙為標準,剪下第二張墻紙。重復上述步聚剪下一批墻紙,在背面寫上粘貼順序。
涂粘合劑
1.把剪下的墻紙疊放在桌上,正面朝下。
2.把最上面的一張墻紙左端拉至桌邊鋪平,右端任其從桌子另一邊垂下。
3.把墻紙左端與桌邊對齊涂上粘合劑。濺在桌上的粘合劑立即用濕布擦掉。有的人喜歡把墻紙邊伸出桌邊約1/4寸,以免粘合劑涂到桌上,不過伸出的部分下面懸空,很難涂刷。
4.將刷子蘸上粘合劑,并在桶口的繩子上刮一下,刮掉過多的粘合劑。
5.沿墻紙中央涂刷一道。
6.再從中央以八字形向兩邊涂刷。
7.檢查粘合劑是否涂勻,有無漏刷,特別是邊上,然后提起墻紙左端,將涂有粘合劑的部分對折,注意不要折出折痕。將墻紙向左拉,使涂過粘合劑的部分掛在桌子左邊。
8.按上述步驟一張張涂上粘合劑,直到全部涂好為止。
9.把右半張紙也對折,這樣首尾兩端正好碰攏,認清哪一頭是上端。裁墻紙時,可在朝上的一頭背面注上“上”字,或每次涂粘合劑先從墻紙朝下的一頭涂起,這樣后折的一定是朝上的一頭。
10.若有粘合劑涂在桌上或裁好的墻紙上,立即用濕布抹掉。
11.涂好粘合劑的墻紙,要按包裝上的說明放置一段時間,以吸收粘合劑中的水分。薄墻紙和乙烯基墻紙,涂好粘合劑后一般馬上可以貼到墻上,較厚的墻紙通常需放置10至15分鐘。若放置時間不夠,貼到墻上后會繼續膨脹或出現氣泡。
12.在第一張墻紙放置吸收水分時,可給其他墻紙涂粘合劑。每張墻紙吸收水分的時間應相同,否則圖案難以對齊。
貼第一張壁紙
貼墻紙要從主要窗戶的鄰墻開始,從亮處向暗處貼過去。這樣,即使墻紙邊縫有交搭,也沒陰影,搭接處不會很明顯。如果有窗戶的墻不止一面,應把最大的窗戶作為主要光源。按以下的步驟,從有主要光源窗戶的墻壁的右側,按順時針方向一張張貼過去。習慣用左手者可以從左側開始。
1.用鉛筆在距墻頂角19寸處作一記號,使墻紙有足夠寬度從這面墻轉貼到有窗戶的墻上。
2.在記號處沿墻懸下一根鉛垂線,用鉛筆沿鉛垂線畫一條標記線。檢查一下標記線與墻角的距離是否上下一致。若墻角不直,在某些地方距離大于19寸,墻紙就沒有足夠的寬度轉貼到毗鄰的墻上。可把鉛垂線向墻角移近些,重畫標記線。
3.把涂好粘合劑的墻紙拿到墻邊,輕輕揭開上端折攏部分,用手拿住兩邊。別讓墻紙的下半部分突然下墜,以免破裂或伸長,無法與其他墻紙對齊。
4.提起墻紙的右上角,使墻紙右邊與標記線對準。
注意:墻紙頂端需留出大約2寸或50毫米長的富裕量,作為修剪之用。
5.把右半張墻紙對準標記線時別讓左半張的邊緣碰到墻面。
6.墻紙右邊對準位置后,用手或刷子向左上角方向抹平墻紙,把左上角也貼到墻上。
7.用刷子自墻紙中心向外把上半部分刷平。墻紙右邊必須與標記線對齊。
8.揭開墻紙下半部折攏部分。首先將中央部分向下刷平,接著以八字形向兩邊刷掉所有氣泡,然后用刷尖或布團輕拍紙邊。
9.墻紙貼好后,再用剪刀的刀背,沿踢腳板邊緣在墻紙上劃出一條明顯的折痕。
10.把墻紙下端輕輕揭起,沿折痕剪齊,然后貼回原處,并且刷平。墻紙上端的修剪步驟相同。
貼其余的壁紙
1.按照貼第一張墻紙的步驟,把第二張墻紙貼在第一張的右側,不必再掛鉛垂線。但左上側幾尺長的邊緣要與已貼好的墻紙邊緣對齊。用手向右上角抹,把墻紙的上部貼在墻上。
2.用刷平墻紙的刷子,將墻紙自中央向四周刷平。
3.揭開墻紙下部的折攏部分,把邊緣與已貼好的墻紙邊緣對齊,用刷子刷平。按上述方法修齊墻紙的上下邊。
4.貼好兩三張后,用壓縫滾筒把各條拼縫輕輕滾壓一遍,但凸紋墻紙不能滾。
美士星
墻紙膠粉 ADHESIVE
200g
COMIC卡米克
墻紙 PVC材質123-125
寬530mm×長10米
RomanRolland
墻紙 32055
寬530mm×長10米
益家
墻紙 YJ566褐底金絲歐花墻紙
寬1.38m
美士星
墻紙基膜 阿迪斯奇高分子墻紙基膜(保護劑)
1L
美士星
墻紙膠粉 阿迪斯奇墻紙粉+環保墻紙純膠
500g(膠)+160g(粉)
Artenis
墻紙 57504
0.53×10M
韓利
墻紙
1.06×15M
時尚元素
墻紙 1297
寬530mm×長10米宏億
墻紙 qz011
0.7×1M美高
墻紙 JB17
0.53×10.05M甜蜜家園
墻紙 HM-1931
寬530mm×長10米OBM
墻紙 50104
寬530mm×長10米皇冠
墻紙 C13903
寬530mm×長10米伊芙琳
墻紙 28303
0.53×10MLG
墻紙 PVC82143-1
1.06×15.5M